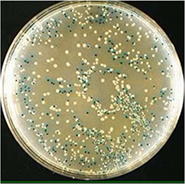

Chất Xgal được sử dụng để xác định sự hoạt động của gene lacZ. Khi gene này
Chất Xgal được sử dụng để xác định sự hoạt động của gene lacZ. Khi gene này hoạt động, enzyme β-galactosidase được tạo ra và phân cắt Xgal thành chất có màu xanh. Vì vậy chất Xgal được sử dụng để phân biệt các dòng vi khuẩn có mang vector tái tổ hợp thành công hoặc không thành công. Nguyên lí là gắn gene cần chuyển vào vị trí ở giữa gene lacZ trên plasmid để tạo ra vector tái tổ hợp, sau đó biến nạp plasmid này vào E. coli (đã bị đột biến mất đoạn gene lacZ trên Operon Lac thuộc DNA vùng nhân) và nuôi các vi khuẩn này trong môi trường bổ sung Xgal. Hình bên minh hoạ khuẩn lạc trên môi trường thạch được bổ sung Xgal. Giả sử hiệu suất biến nạp là 100%, hãy cho biết những phát biểu nào sau đây đúng?
1) Nên sử dụng khuẩn lạc màu trắng như trong hình để nhân dòng và đem nuôi cấy nhằm thu sản phẩm của gene cần chuyển.
2) Trong trường hợp vi khuẩn chứa plasmid không mang gene cần chuyển thì gene lacZ của plasmid và gene lacZ của Operon thuộc DNA vùng nhân vẫn phiên mã bình thường.
3) Các khuẩn lạc có màu xanh như trong hình đều là các vi khuẩn không mang gene cần chuyển.
4) Nếu chuyển plasmid có mang gene cần chuyển vào chủng E. coli kiểu dại không bị đột biến và nuôi cấy trên môi trường thạch có bổ sung Xgal thì khuẩn lạc sẽ có màu trắng.
Đáp án đúng là: 24
Quảng cáo
Đọc và phân tích dữ kiện đề bài.
Đáp án cần điền là: 24
>> 2K9 Chú ý! Lộ Trình Sun 2027 - 1 lộ trình ôn đa kỳ thi (TN THPT, ĐGNL (Hà Nội/ Hồ Chí Minh), ĐGNL Sư Phạm, ĐGTD, ĐGNL Bộ Công an, ĐGNL Bộ Quốc phòngTD - Click xem ngay) tại Tuyensinh247.com. Cập nhật bám sát bộ SGK mới, Thầy Cô giáo giỏi, 3 bước chi tiết: Nền tảng lớp 12; Luyện thi chuyên sâu; Luyện đề đủ dạng đáp ứng mọi kì thi.
![]() |
![]() |
![]() |
![]() |
![]() |
![]() |
![]() |
![]() |
Hỗ trợ - Hướng dẫn
-
024.7300.7989
-
1800.6947
(Thời gian hỗ trợ từ 7h đến 22h)
Email: lienhe@tuyensinh247.com












